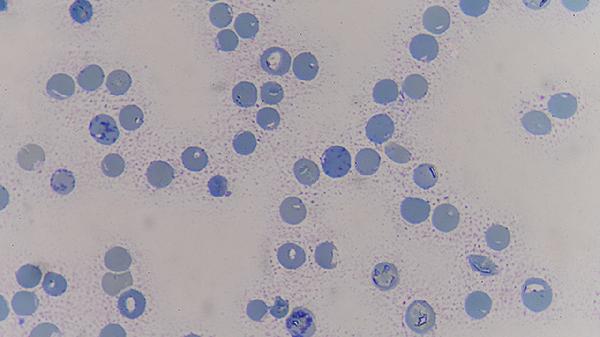
从明年开始，超过52岁以上的癌症患者，一定要做好这4个准备

从明年开始,超过52岁以上的癌症患者,一定要做好这4个准备
头发还没白透,体检报告先亮红灯?最.近后台总收到同龄朋友的私信:年轻时熬夜蹦迪都不怕,现在连喝冰美式都犹豫三分钟。尤其看到身边有人查出问题,瞬间觉得养生flag必须立刻马上立起来!但预防不是临时抱佛脚,特别是过了50岁这道坎,有些准备真的越早做越踏实。
一、筛查计划要升级
1.常规项目别偷懒
胃肠镜从三年一检缩短到两年,低剂量肺部CT记得纳入年度套餐。50岁后脏器功能就像老房子电路,定期巡检才能发现隐藏线路老化。
2.关注肿瘤标志物
CA125、CEA这些数值要和历年报告纵向对比,单次超标先别慌,但连续三次箭头向上就要敲警.钟。
3.基因检测做规划
有家族史的可以做个简单易感基因筛查,不是为制造焦虑,而是为定制个性化监测方案。
二、免疫系统要充值
1.营养密度优先
减少空热量食物,每餐保证优质蛋白+深色蔬菜的组合拳。中年代谢慢了,但营养需求反而增加30%。
2.肠道菌群保养
发酵食品和膳食纤维就是益生菌的豪华套餐,没必要追求昂贵补充剂,每天300g无糖酸奶加一把燕麦就够用。
3.睡眠质量监测
戴个手环记录深睡眠时长,长期低于1.5小时要考虑调节褪黑素分泌,免疫细胞都在后半夜增殖练兵。
三、医疗信息要归档
1.检查报告电子化
把所有影像胶片拍照存网盘,血检报告做成Excel趋势图。关键时刻医生调取资料快一分钟,决策就精准一分。
2.药物清单随身带
正在吃的营养素和慢性.病药物列清单存手机备忘录,突发情况时避免药物相互作用风险。
3.就医绿色通道
提前了解三甲医院特需门诊预约规则,保留两三家不同等级医院的可靠联络方式。
四、心理账户要存款
1.建立支持系统
参加正.经的健康社群比在养生群抢红包靠谱,找到三五个能讨论严肃健康话题的同龄伙伴。
2.调整健康期待值
接受体检指标的正常浮动范围变宽,重点关注变化趋势而非绝对值,就像看待股票大盘而不是个股。
3.培养正向应激
遇到异常指标先做三次深呼吸,把焦虑能量转化为预约复查的行动力,恐惧往往来自未知空白区。
这些准备不是为制造恐慌,恰恰是为了消除恐慌。就像出门前检查手机电量,不是预测会断电,而是为了一路安心。真正的养生自由,是把健康管理变成像刷牙洗脸一样的日常仪式感。